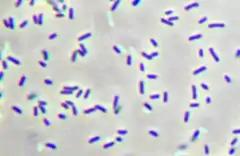

Зелені сірчані бактерії
Chlorobiaceae або зелені сірчані бактерії — родина облігатно аеробних фотоавтотрофних бактерій. Вони найближчі за походженням до типу Bacteroidetes, проте достатньо відмінні, і, таким чином, класифікуються до окремого типу[1].
? Chlorobiaceae | ||||||||||||
|---|---|---|---|---|---|---|---|---|---|---|---|---|
![]() Chlorobium tepidum | ||||||||||||
| Біологічна класифікація | ||||||||||||
| ||||||||||||
Роди | ||||||||||||
| ||||||||||||
Посилання | ||||||||||||
| ||||||||||||
Зелені сірчані бактерії нерухомі (за винятком Chloroherpeton thalassium, який може проявляти бактеріальне ковзання)[1] та мають форму сфер, паличок та спіралей. Фотосинтез відбувається із використанням бактеріохлорофілу (BChl) c, d або e, на додаток до BChl a і хлорофілу a[1]. Ці бактерії використовують сульфідні іони, водень або іони заліза як донора електронів, цей процес відбувається за допомогою реакціонного центру I типу і комплексу Фенни-Метьюса-Ольсона. Елементарна сірка, що відкладається за межами клітинної стінки, може бути ще більше окислена. На відміну від них, фотосинтез рослин використовує воду як донора електронів та призводить до утворення кисню[1].
Chlorobium tepidum використовується як модельний організм цієї групи. Нині секвеновані геноми десяти представників групи, що дуже багато для різноманітності родини. Ці геноми мають розміри у 2-3 Mbp та кодують 1750—2800 генів, 1400—1500 яких загальні для всіх штамів. У цих бактерій відсутні двокомпонентні гістидинові-кінази та регулятори відповіді, що пропонує обмежену фенотипічну пластичність. Незначна залежність цих бактерій від транспортерів органічнних речовин і факторів транскрипції також указує на адаптованість цих організмів до вузької екологічної ніши з обмеженими джерелами енергії, подібно до ціанобактерій Prochlorococcus і Synechococcus[1].
Види зелених сірчаних бактерій були знайдені в воді біля гідротермальних джерел біля тихоокеанського узбережжя Мексики на глибіні до 2 500 м. На цій глибіні, куди не досягає сонячне світло, бактерії, позначені GSB1, живуть за рахунок сяйва гідротермального джерела[2]
Посилання
- D.A. Bryant & N.-U. Frigaard (Nov 2006). Prokaryotic photosynthesis and phototrophy illuminated. Trends Microbiol. 14 (11): 488. doi:10.1016/j.tim.2006.09.001.
- Beatty JT, Overmann J, Lince MT, Manske AK, Lang AS, Blankenship RE, Van Dover CL, Martinson TA, Plumley FG. (2005). An obligately photosynthetic bacterial anaerobe from a deep-sea hydrothermal vent. Proc. Natl Acad. Sci. USA 102 (26): 9306–10. PMID 15967984.
- The Family Chlorobiaceae. The Prokaryotes. Архів оригіналу за 17 листопада 2003. Процитовано July 5 2005.